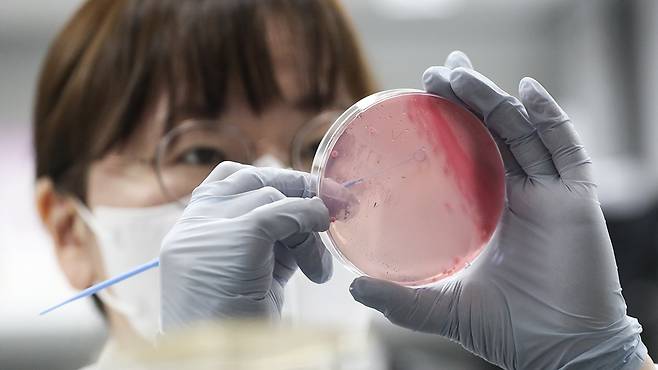
뉴스1

[포토타임]삼바 댄스로 물들인 명동거리, 롯데월드 '시티 바캉스&삼바'
오늘의 국내 주요 뉴스 사진(전송시간 기준)을 한눈에 파악할 수 있도록 실시간 업데이트합니다.
■ 오후 1:15 삼바 댄스로 물들인 명동거리, 롯데월드 '시티 바캉스&삼바' 19일 서울 중구 명동 유네스코 거리에서 롯데월드 어드벤처 삼바 공연 연기자들이 특별 거리 공연을 하고 있다. 롯데월드 어드벤처는 지난 7일부터 시티팝과 삼바의 만남을 통해 이국적인 분위기를 느낄 수 있는 여름 축제 '시티 바캉스 & 삼바'를 진행하고 있다. 오는 9월 1일까지 롯데월드에서 열리는 이번 여름 축제는 메인 공연인 '삼바 카니발 퍼레이드'를 비롯해 남미 특유의 에너지를 느낄 수 있는 댄스 스테이지 공연 '삼바 투게더', '삼바 스텝 스쿨' 등 다채로운 공연과 이국적인 콘텐츠 등으로 꾸려져 있다.






■ 2024.06.19 오후 1:00 여름철 식중독 주의, 예방도 철저히 19일 경기 수원시 권선구 경기도보건환경연구원에서 감염병연구부 수인성질환팀 직원이 식중독균 배양검사를 하고 있다. 식중독은 인체에 유해한 미생물 또는 유독 물질이 들어있는 식품의 섭취로 인하여 발생하였거나 발생한 것으로 판단되는 감염성 또는 독소형 질환으로 높은 기온에 음식물이 상하기 쉬운 여름에 주로 발생한다. 예방을 위해서는 6대 수칙인 ▲손 씻기 ▲구분 사용하기 ▲익혀먹기 ▲세척·소독하기 ▲끓여먹기 ▲보관온도 지키기를 철저히 준수해야 한다.

■ 2024.06.19 오후 12:40 롯데호텔앤리조트, 'L7 해운대' 그랜드 오픈 롯데호텔앤리조트는 19일 부산 해운대 우동 L7 해운대에서 호텔 오픈을 기념하는 그랜드 오픈 행사를 가졌다. L7 해운대는 부산 해운대해수욕장 앞에 해수욕장 조망을 갖춘 4성급 부티크 호텔이다. 383개 규모 객실을 갖췄다. 4성급 호텔임에도 불구하고 5성급 호텔보다 규모가 큰 옥상 수영장(사계절 이용 가능)도 갖췄다. 사진은 이날 행사에 참석한 왼쪽부터 서광일 L7 해운대 총지배인, 이효섭 롯데호텔앤리조트 리조트&CL본부장, 홍성준 부산롯데호텔 대표이사, 김태홍 롯데호텔앤리조트 대표이사, 이정실 부산관광공사 사장, 손수득 벡스코 대표이사, 임미화 본푸드 대표이사, 조용성 롯데호텔앤리조트 CL부문장이 개장 축하 리본 커팅식을 하고 있다.




■ 2024.06.19 오후 12:30 물살 가르며 해상 돌격하는 해병대 KAAV 19일 경북 포항시 남구 도구 해안에서 열린 해병대 1사단 상장대대 훈련에서 한국형상륙돌격장갑차(KAAV)가 돌진하고 있다. 이번 훈련은 유사시 해군 상륙지원함인 비로봉함(LST-682)을 이용, 신속한 작전지역으로 이동하기 위한 훈련이다.




■ 2024.06.19 오후 12:15 '도심 속 워터파크' 한강 수영장·물놀이장 20일 개장 19일 서울 영등포구 양화 한강공원 물놀이장에서 관계자들이 개장 준비를 하고 있다. 서울시는 오는 20일부터 8월 18일까지 뚝섬·여의도·잠원한강공원 수영장과 잠실·양화·난지한강공원 물놀이장 6곳을 운영한다. 한강공원 수영장·물놀이장은 운영 기간 매일 오전 9시부터 오후 6시까지 문을 연다. 새로 문 연 잠실 물놀이장은 오후 8시까지 이용할 수 있다. 이용요금은 수영장의 경우 어린이 3천원, 청소년 4천원, 성인 5천원이며 물놀이장은 어린이 1천원, 청소년 2천원, 성인 3천원이다. 6세 미만은 무료다.




■ 2024.06.19 오후 12:00 낮 최고 36도 무더위 지속...제주 밤부터 장맛비 19일 부산 해운대해수욕장을 찾은 국내·외 관광객들이 물놀이와 선텐을 하며 더위를 식히고 있다. 기상청은 이날 전국 대부분 지역에서 낮 기온이 33도 내외(내륙 중심 35도 안팎)로 오르는 곳이 많아 덥겠다고 예보했다. 특히 폭염특보가 발효된 수도권과 강원 영서 중부, 충청권 내륙, 남부지방을 중심으로는 최고체감온도가 33도 안팎으로 더욱 높겠으니 온열질환 발생에 각별히 유의해야겠다. 낮 최고기온은 서울 35도, 인천 31도, 수원 33도, 춘천 34도, 강릉 33도, 청주 35도, 대전 35도, 전주 35도, 광주 35도, 대구 36도, 부산 31도, 제주 29도다. 제주도에는 늦은 밤부터 비가 50~100㎜, 산지에 최고 200㎜ 이상 내리겠다. 미세먼지 농도는 전 권역이 '좋음'∼'보통'으로 전망된다.




■ 오전 9:00 '잠수함 킬러' 최신예 해상초계기-Ⅱ P-8A 국내 도착 해군은 세계 최고 잠수함 킬러인 최신예 해상초계기-Ⅱ 'P-8A 포세이돈' 3대가 19일 포항 해군항공사령부에 도착했다고 밝혔다. 해군과 방위사업청에 따르면 군은 2018년 9월부터 P-8A 도입을 계획한 이후 미국 보잉사에서 지난해까지 6대를 생산했다. 이후 미국 현지 인수, 운용 요원들의 국외 인수 교육을 마치고 이날 3대가 먼저 한국에 도착하게 됐다. 나머지 3대는 오는 30일에 도착한다.
P-8A는 최대속도는 시속 907㎞로 해군의 기존 해상초계기인 P-3(시속 749㎞)보다 빠르고, 작전반경도 넓다. 최대 수백km 떨어진 해상표적을 탐지할 수 있는 장거리 X밴드 레이더, 수십km 거리 표적을 고해상도로 촬영·탐지할 수 있는 디지털 전자광학(EO)/적외선(IR) 장비 등 고성능 감시정찰 장비와 전자전 장비를 탑재하고 있다. 또 해상표적을 정밀 타격할 수 있는 공대함 유도탄과 수중 잠수함을 타격할 수 있는 어뢰 등 무장을 장착하고 있으며, 적 잠수함 신호를 탐지하고 식별·추적할 수 있는 음향탐지 부표(소노부이)를 120여 발 실을 수 있다. P-8A는 앞으로 1년간의 작전 수행능력 평가를 거친 후 내년 중반부터 작전 현장에 투입된다.
사진은 지난 2월 2일 양용모 해군참모총장이 미 잭슨빌 해군기지에 방문해 미국에서 교육중인 한국 해군 P-8A 인수/운용인원들과 한국해군 P-8A 해상초계기를 배경으로 기념촬영 하는 모습.





김종호 기자 kim.jongho1@joongang.co.kr
Copyright © 중앙일보. 무단전재 및 재배포 금지.
- 햇반까지 비닐에 욱여넣었다…동생의 고독사, 누나의 ‘득템’ | 중앙일보
- 모친 살해한 '전교1등' 아들, 13년 만에 고백 "두 아이 아빠 됐다" | 중앙일보
- "왜 신차 비닐 안 뜯습니까"...현대차 싹 뜯은 '정의선 스타일' | 중앙일보
- 톱스타 한명 없는데 시청률 터졌다…'우영우' 이은 대박 드라마 | 중앙일보
- "1억 주면 조용히 있겠다"…공정위 신고전 백종원 압박한 점주들 | 중앙일보
- 60대 할머니 몰던 차, 주차장 벽에 '쾅'…10개월 손자 숨졌다 | 중앙일보
- "중국인 왜 남의 나라 더럽히나"…제주 도로서 바지 벗고 대변 '충격' | 중앙일보
- "촉감 궁금해" 노골적 성적요구 강요받았다…하남 교제살인 전말 | 중앙일보
- 팀 동료가 손흥민 인종차별…토트넘 침묵에 서경덕 "FIFA 고발" | 중앙일보
- "부친과 보기 좋았는데…" 이 질문에 박세리 눈물, 수십초 침묵 | 중앙일보